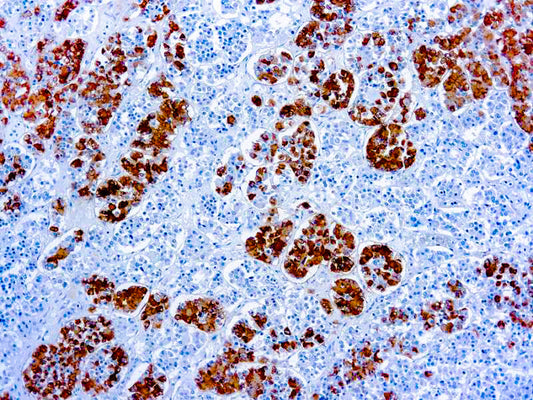
Adrenocorticotropic Hormone (ACTH) - (AH26)

Collection: Diagnostic Biosystems
Diagnostic BioSystems provides cutting-edge in-vitro diagnostics to the anatomic pathology and histology market. Product portfolio includes high quality primary and fluorescent antibodies (CF488 and FITC conjugated), autostainer, chromogens, detection kits and a wide range of ancillaries.
Diagnostic BioSystems is an ISO 13485:2016 certified cGMP compliant, medical device manufacturer.
-
CD79a B-Cell
Vendor:DbiosysRegular price $828.00 USDRegular priceUnit price / per -
CD79a B-Cell
Vendor:DbiosysRegular price $126.00 USDRegular priceUnit price / per -
CD79a B-Cell
Vendor:DbiosysRegular price $496.00 USDRegular priceUnit price / per -
Adrenocorticotropic Hormone (ACTH) - (AH26)
Vendor:DbiosysRegular price $621.00 USDRegular priceUnit price / per -
Adrenocorticotropic Hormone (ACTH) - (AH26)
Vendor:DbiosysRegular price $88.00 USDRegular priceUnit price / per -
Adrenocorticotropic Hormone (ACTH) - (AH26)
Vendor:DbiosysRegular price $376.00 USDRegular priceUnit price / per -
Androgen Receptor
Vendor:DbiosysRegular price $694.00 USDRegular priceUnit price / per -
Androgen Receptor
Vendor:DbiosysRegular price $105.00 USDRegular priceUnit price / per -
Androgen Receptor
Vendor:DbiosysRegular price $420.00 USDRegular priceUnit price / per -
CD44 H Cam
Vendor:DbiosysRegular price $634.00 USDRegular priceUnit price / per -
CD44 H Cam
Vendor:DbiosysRegular price $97.00 USDRegular priceUnit price / per -
CD44 H Cam
Vendor:DbiosysRegular price $380.00 USDRegular priceUnit price / per -
CD56 NCAM-1
Vendor:DbiosysRegular price $499.00 USDRegular priceUnit price / per -
CD56 NCAM-1
Vendor:DbiosysRegular price $88.00 USDRegular priceUnit price / per -
CD56 NCAM-1
Vendor:DbiosysRegular price $300.00 USDRegular priceUnit price / per -
Cyclin E Protein
Vendor:DbiosysRegular price $740.00 USDRegular priceUnit price / per -
Cyclin E Protein
Vendor:DbiosysRegular price $112.00 USDRegular priceUnit price / per -
Cyclin E Protein
Vendor:DbiosysRegular price $444.00 USDRegular priceUnit price / per